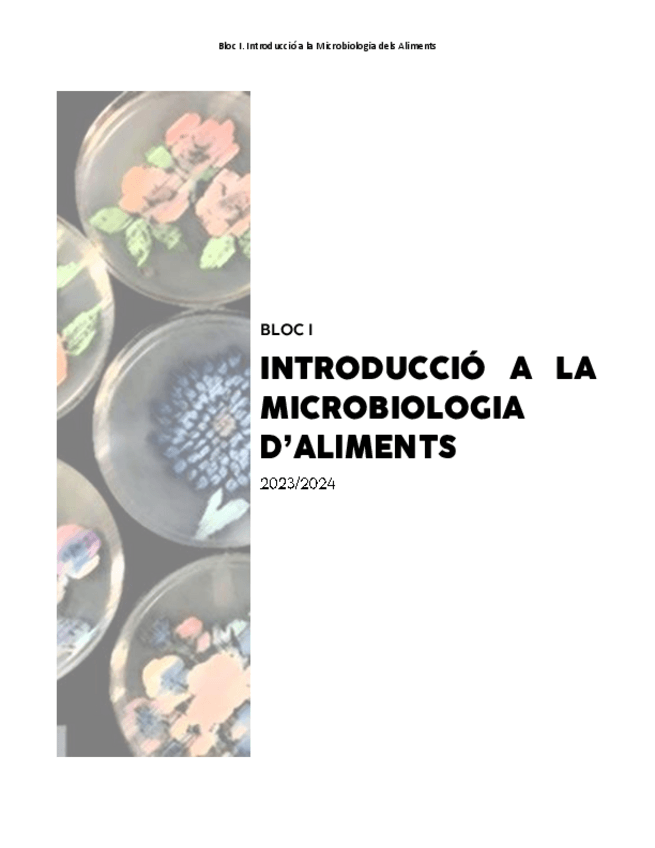

Microbiologia i Parasitologia d'Aliments
He publicado nuevos apuntes de 2º Microbiologia i Parasitologia d'Aliments: casos-practics-analisis-microbiologic-dels-aliments-tema-3-microbiologia-2025-2026.pdf
He publicado nuevos apuntes de 2º Microbiologia i Parasitologia d'Aliments: taula-resum-parasits-primer-parcial-parasitologia-2025-2026.pdf
He publicado nuevos apuntes de 2º Microbiologia i Parasitologia d'Aliments: problemes-control-microorganismes-primer-parcial-microbiologia-2025-2026.pdf
He publicado nuevos examenes de 2º Microbiologia i Parasitologia d'Aliments: PARASITOLOGIA-1R-PARCIAL.pdf
He publicado nuevos apuntes de 2º Microbiologia i Parasitologia d'Aliments: Resum-Examen-Final-Parasitologia.pdf
He publicado nuevos apuntes de 2º Microbiologia i Parasitologia d'Aliments: Resum-Examen-Final-Microbiologia-dels-Aliments.pdf
He publicado nuevos apuntes de 2º Microbiologia i Parasitologia d'Aliments: Resum-Bloc-2.pdf
He publicado nuevos apuntes de 2º Microbiologia i Parasitologia d'Aliments: Resum-Bloc-1.pdf
He publicado nuevos apuntes de 2º Microbiologia i Parasitologia d'Aliments: APUNTS-PARASITOLOGIA-DELS-ALIMENTS-TOT-TEMARI.pdf
apuntes
-
APUNTS PARASITOLOGIA DELS ALIMENTS
He publicado nuevos apuntes de 2º Microbiologia i Parasitologia d'Aliments: APUNTS PARASITOLOGIA DELS ALIMENTS
He publicado nuevos apuntes de 2º Microbiologia i Parasitologia d'Aliments: APUNTS-MICROBIOLOGIA-DALIMENTS-TOT-TEMARI.pdf
apuntes
-
APUNTS MICROBIOLOGIA DELS ALIMENTS
He publicado nuevos apuntes de 2º Microbiologia i Parasitologia d'Aliments: APUNTS MICROBIOLOGIA DELS ALIMENTS
He publicado nuevos apuntes de 2º Microbiologia i Parasitologia d'Aliments: tabla-de-parasitos-en-microbiologia-2025.xlsx
apuntes
-
Tots els apunts 2025
He publicado nuevos apuntes de 2º Microbiologia i Parasitologia d'Aliments: Tots els apunts 2025
examenes
-
Cas practic 2025
He publicado nuevos examenes de 2º Microbiologia i Parasitologia d'Aliments: Cas practic 2025
examenes
-
Examen Parcial o questionari Parasitologia2025
He publicado nuevos examenes de 2º Microbiologia i Parasitologia d'Aliments: Examen Parcial o questionari Parasitologia2025
He publicado nuevos examenes de 2º Microbiologia i Parasitologia d'Aliments: Socrative-preguntas.pdf
He publicado nuevos examenes de 2º Microbiologia i Parasitologia d'Aliments: PREGUNTAS-EXAMEN-copia-presentacion.pdf
apuntes
-
Apuntes micro+parasito
He publicado nuevos apuntes de 2º Microbiologia i Parasitologia d'Aliments: Apuntes micro+parasito
apuntes
-
Microbiologia Apunts
He publicado nuevos apuntes de 2º Microbiologia i Parasitologia d'Aliments: Microbiologia Apunts
He publicado nuevos apuntes de 2º Microbiologia i Parasitologia d'Aliments: TAULA-RESUM-BACTERIS.pdf
He publicado nuevos apuntes de 2º Microbiologia i Parasitologia d'Aliments: 13-Socrative-micro-corregidopdf240415093939.pdf
He publicado nuevos apuntes de 2º Microbiologia i Parasitologia d'Aliments: Socrative-Ecologia-Microbiana-en-Aliments240609212220.pdf
He publicado nuevos apuntes de 2º Microbiologia i Parasitologia d'Aliments: TABLA-CUCS.pdf
apuntes
-
APUNTS MICRO PER BLOCS
He publicado nuevos apuntes de 2º Microbiologia i Parasitologia d'Aliments: APUNTS MICRO PER BLOCS
He publicado nuevos apuntes de 2º Microbiologia i Parasitologia d'Aliments: Taula-parasits.pdf
He publicado nuevos apuntes de 2º Microbiologia i Parasitologia d'Aliments: Taula-bacteris.pdf
He publicado nuevos apuntes de 2º Microbiologia i Parasitologia d'Aliments: TEMA-7.1.-Protozous.pdf
He publicado nuevos apuntes de 2º Microbiologia i Parasitologia d'Aliments: TEMA-9-Artropodes.pdf
He publicado nuevos apuntes de 2º Microbiologia i Parasitologia d'Aliments: TEMA-10-Control.pdf
He publicado nuevos apuntes de 2º Microbiologia i Parasitologia d'Aliments: 6.-Introduccio-a-la-parasitologia-dels-aliments.pdf
He publicado nuevos apuntes de 2º Microbiologia i Parasitologia d'Aliments: Helmints-7.2.-Trematodes-digenids.pdf
He publicado nuevos apuntes de 2º Microbiologia i Parasitologia d'Aliments: Resum-Helmints.pdf
He publicado nuevos apuntes de 2º Microbiologia i Parasitologia d'Aliments: Helmints-7.3.-Cestodes.pdf
He publicado nuevos apuntes de 2º Microbiologia i Parasitologia d'Aliments: Helmints-7.4.-Nematodes.pdf
He publicado nuevos apuntes de 2º Microbiologia i Parasitologia d'Aliments: PARASITOLOGIA.pdf
apuntes
-
Parasitologia Apunts
He publicado nuevos apuntes de 2º Microbiologia i Parasitologia d'Aliments: Parasitologia Apunts
He publicado nuevos examenes de 2º Microbiologia i Parasitologia d'Aliments: questionari-tema-2-micro.pdf
He publicado nuevos examenes de 2º Microbiologia i Parasitologia d'Aliments: questionari-tema-1.pdf
He publicado nuevos apuntes de 2º Microbiologia i Parasitologia d'Aliments: apunts-parasitologia-tot.pdf
He publicado nuevos apuntes de 2º Microbiologia i Parasitologia d'Aliments: Microbiologia-aliments-tot.pdf
He publicado nuevos apuntes de 2º Microbiologia i Parasitologia d'Aliments: Taula-resum-parasitologia.pdf
He publicado nuevos apuntes de 2º Microbiologia i Parasitologia d'Aliments: Parasitologia-tot-el-temari.pdf
He publicado nuevos apuntes de 2º Microbiologia i Parasitologia d'Aliments: Protozous.pdf
He publicado nuevos apuntes de 2º Microbiologia i Parasitologia d'Aliments: Control.pdf
He publicado nuevos apuntes de 2º Microbiologia i Parasitologia d'Aliments: artropodes.pdf
He publicado nuevos apuntes de 2º Microbiologia i Parasitologia d'Aliments: nematodes.pdf
He publicado nuevos apuntes de 2º Microbiologia i Parasitologia d'Aliments: CESTODES.pdf
He publicado nuevos apuntes de 2º Microbiologia i Parasitologia d'Aliments: Trematodes-digenids.pdf
He publicado nuevos apuntes de 2º Microbiologia i Parasitologia d'Aliments: Aspectes-generals-parasitologia.pdf
He publicado nuevos apuntes de 2º Microbiologia i Parasitologia d'Aliments: tema-5.pdf
He publicado nuevos apuntes de 2º Microbiologia i Parasitologia d'Aliments: SEGON-PARCIAL.pdf
He publicado nuevos apuntes de 2º Microbiologia i Parasitologia d'Aliments: PIRMER-PARCIAL.pdf
He publicado nuevos examenes de 2º Microbiologia i Parasitologia d'Aliments: POSSIBLES-PREGUNTES-MICROBIO.pdf
He publicado nuevos apuntes de 2º Microbiologia i Parasitologia d'Aliments: MICROBIOLOGIA-APUNTS-TOT.pdf
He publicado nuevos apuntes de 2º Microbiologia i Parasitologia d'Aliments: Resums-parasitologia-1r-examen.pdf
He publicado nuevos apuntes de 2º Microbiologia i Parasitologia d'Aliments: TEMA-3.1.pdf
He publicado nuevos ejercicios de 2º Microbiologia i Parasitologia d'Aliments: Questionaris-Socrative.pdf